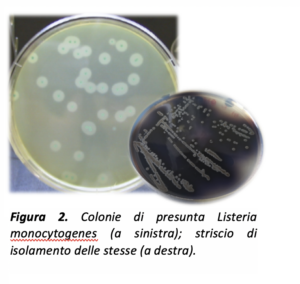

Monitoraggio microbiologico di olive da tavola commerciali
Flora Valeria Romeo, Gloria Sciuto, Paola Foti,

I metodi di trasformazione delle olive hanno come obiettivo primario la rimozione del gusto amaro, che è naturalmente presente in questo frutto. Nella maggior parte dei metodi di trasformazione, viene avviato un processo fermentativo per aumentare l’appetibilità del prodotto finale, anche dopo l’eventuale uso di sostanze chimiche. Le olive verdi sono prevalentemente trasformate secondo il metodo Sivigliano, oppure con il metodo Castelvetrano, che fanno entrambi uso di soda che ne accorcia enormemente i tempi di deamarizzazione; mentre, le olive nere sono processate secondo il metodo greco, o fermentazione naturale in presenza di sale, oppure seguendo il metodo Californiano. In molti casi, la fermentazione spesso è l’unica procedura applicata per la conservazione delle olive da tavola e spesso, a livello locale, fioriscono ricette diverse che conferiscono tipicità al prodotto.
Il progetto DEAOLIVA “Miglioramento della qualità, sostenibilità e sicurezza d’uso nella deamarizzazione delle olive da tavola attraverso processi innovativi a scala pilota”, è stato finanziato dal MiPAAF, attuale MASAF, e coordinato dalla dott.ssa Barbara Lanza del CREA-IT (sito internet: QUI). Il progetto, che si è appena concluso, ha avuto tra gli obiettivi il miglioramento della sicurezza alimentare, l’aspetto salutistico delle olive da tavola e l’ecosostenibilità dei sistemi produttivi.
Per comprendere le problematiche del settore delle olive da tavola, gli autori hanno ritenuto necessario effettuare un monitoraggio pluriennale dei prodotti commerciali al fine di analizzare i punti critici ed apportare soluzioni attraverso il contributo della ricerca. La qualità igienica delle olive da tavola riveste un ruolo fondamentale per garantire la massima sicurezza per il consumatore. In particolare, le attività microbiologiche svolte si sono focalizzate sul controllo della qualità dei prodotti fermentati attraverso analisi microbiologiche e chimiche, ponendo particolare attenzione al rilevamento di microrganismi potenzialmente patogeni e/o micotossigeni.
Per quattro anni consecutivi, sono state effettuate analisi su campioni commerciali di cultivar Nocellara del Belice, Nocellara etnea, Bella di Cerignola, Itrana Bianca, Conservolea nera e Hojiblanca nera (Figura 1), intere, schiacciate o denocciolate, che sono state preparate tramite diversi metodi di trasformazione: Castelvetrano, Sivigliano, fermentazione naturale e Californiano. Sono state analizzate quattro cultivar l’anno, ognuna delle quali confezionata in tre lotti differenti.

Tutti i campioni sono stati sottoposti a misurazione del pH per valutare l’andamento della fermentazione e per attestare se il prodotto avesse raggiunto un valore di pH di sicurezza per il consumatore. Come si osserva nel Grafico 1, solo i tre metodi che fanno uso di soda oltrepassano sempre il valore di pH di sicurezza oppure lo toccano solo in alcuni casi, come per il Sivigliano. I campioni trattati con metodo naturale restano tutti sotto un valore di 4,5 per tutti i campionamenti effettuati.

Sono state condotte analisi di routine circa la quantificazione della carica di batteri lattici, conta mesofila totale, lieviti e muffe. Inoltre, analisi quali-quantitative di alcuni patogeni sono state condotte sui campioni al fine di monitorare l’igiene del prodotto finito. Le analisi microbiologiche sono state condotte sulle salamoie o sulle drupe, in presenza di campioni che non contenevano liquido di governo (ad es. olive trattate con metodo californiano), ed espresse in logaritmo di Unità Formanti Colonie (UFC).

I valori di lieviti e muffe (Grafico 2) sono in linea con i dati del settore, ed in generale non destano preoccupazione in campioni fermentati. I batteri lattici, che sono positivi nelle fermentazioni e per la salute del consumatore, raggiungono tutti valori alti tranne, sorprendentemente, nei campioni naturali. I motivi possono essere diversi, e vanno dalle tecniche di conduzione del campo fino alla manipolazione delle olive da parte dell’operatore. La valutazione della conta mesofila aerobia totale è utilizzata come indicatore della qualità igienica complessiva dei processi di produzione degli alimenti. Quindi, il metodo Castelvetrano e quello Californiano destano in tal senso preoccupazione e necessità di monitorare eventuali patogeni. Infatti, guardando i risultati dei Grafici 2 e 3, sono i due metodi che hanno presentato risultati più simili ed il maggiore contenuto di patogeni potenziali. I batteri coliformi hanno raggiunto quantità indesiderate soprattutto con il metodo Californiano. La popolazione dei coliformi in genere scompare nelle olive e nelle salamoie solo se il pH si acidifica fino a livelli di sicurezza (<4,5) in tempi brevi. Infatti, se la diminuzione del pH durante i primi giorni della fermentazione non è abbastanza rapida, il deterioramento delle olive può insorgere rapidamente, a causa di questi e altri gruppi microbici che possono raggiungere alte densità cellulari. Riguardo a Listeria spp., una trentina di ceppi isolati, potenzialmente appartenenti a L. monocytogenes, dopo caratterizzazione fortunatamente sono risultati appartenere ad altre specie di Listeria.

Oltre ai risultati mostrati nei grafici, le analisi microbiologiche effettuate sui campioni commerciali nel corso dei quattro anni hanno mostrato l’assenza di muffe micotossigene, con l’eccezione di un solo lotto di Nocellara del Belice trattata col metodo Castelvetrano, in cui si è registrata una carica molto bassa. Invece, Clostridium perfringens è risultato sempre assente in tutti i campionamenti.
In conclusione, il metodo Castelvetrano ha mostrato dati più simili al californiano. Dai risultati ottenuti si evidenzia quindi la necessità di controllare il pH dei campioni per garantire un prodotto sicuro per il consumatore. L’acidità di un prodotto, infatti, è il primo ostacolo che può contenere enormemente le cariche microbiche e soprattutto i patogeni. Nel caso in cui i risultati del monitoraggio indichino un aumento del pH o un’alta presenza di microrganismi indesiderati, agenti di spoilage o potenziali patogeni, è necessario intervenire tempestivamente per salvaguardare la qualità del prodotto.
Gli Autori del presente articolo fanno parte del Consiglio per la Ricerca in agricoltura e l’analisi dell’Economia Agraria-Centro di ricerca Olivicoltura, Frutticoltura e Agrumicoltura (CREA), C.so Savoia 190, 95024, Acireale (Catania), Italia.
Il lavoro è stato svolto con il progetto DEAOLIVA finanziato dal Ministero dell’Agricoltura, della Sovranità alimentare e delle Foreste (D.M. 93882/2017 e D.M. 35902/2019).
In apertura: olive, foto Plum per Olio Officina
Per commentare gli articoli è necessario essere registrati
Se sei un utente registrato puoi accedere al tuo account cliccando qui
oppure puoi creare un nuovo account cliccando qui


Commenta la notizia
Devi essere connesso per inviare un commento.